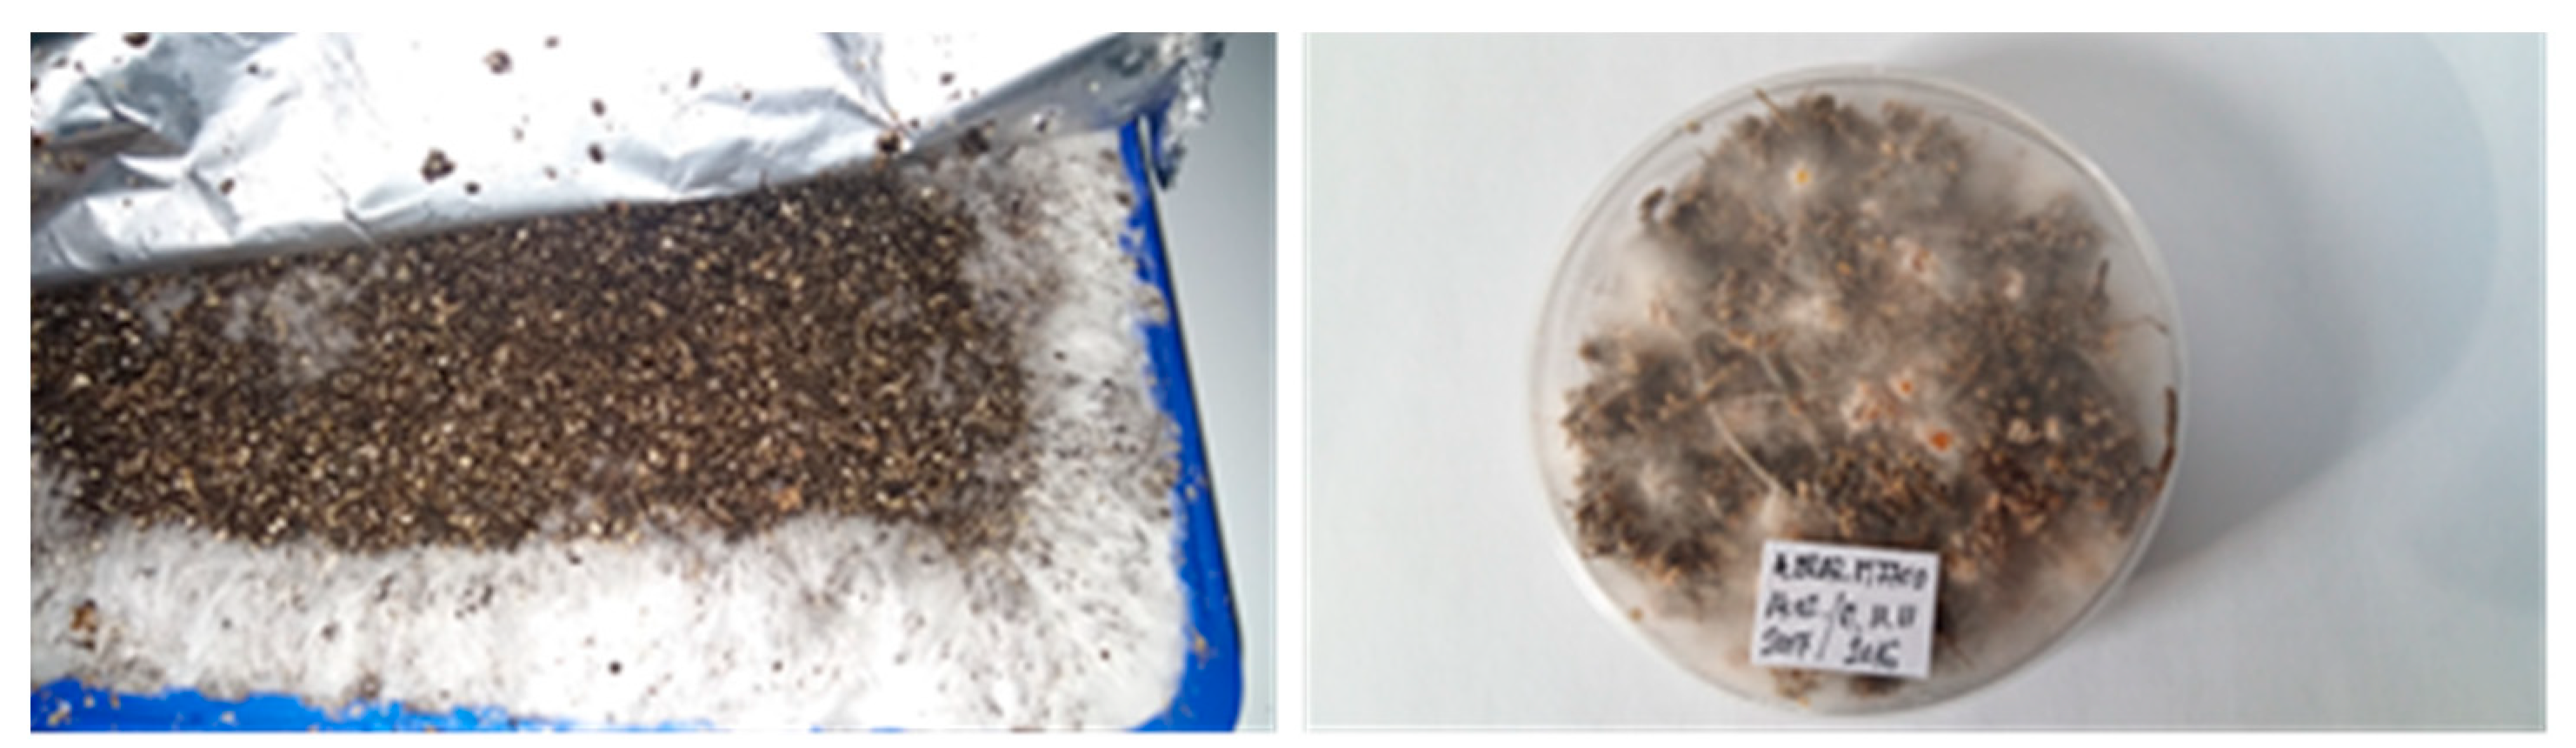
Plants 08 00316 g0a4

Influence of the Culture Substrate on the Agaricus blazei Murrill Mushrooms Vitamins Content
Abstract
1. Introduction
2. Results
2.1. Ergosterol Content of Agaricus blazei Murrill Mushrooms (mg 100 g−1 dm)
2.2. Vitamin C Content of Agaricus blazei Murrill Mushrooms (mg 100 g−1 dm)
2.3. B1 Vitamin (Thiamin) Content of Agaricus blazei Murrill Mushrooms (μg 100 g−1 dm)
2.4. Vitamin B2 (Thiamin) Content of Agaricus blazei Murrill Mushrooms (μg 100 g−1 dm)
2.5. Vitamin B9 (Folic Acid) Content of Agaricus blazei Murrill Mushrooms (μg 100 g−1 dm)
2.6. Vitamin B12 (Cobalamin) Content of Agaricus blazei Murrill Mushrooms (μg 100 g−1 dm)
2.7. PP Vitamin (B3—niacin) Content of Agaricus blazei Murrill Mushrooms (mg 100 g−1 dm)
3. Discussion
4. Materials and Methods
4.1. Biological Material Used in Experiments
4.2. Experimental Factors
4.3. Standards and Reagents
4.4. Samples Preparation
4.5. Sample Extraction
4.6. Methods Used for Analyses
4.7. Statistical Analysis
5. Conclusions
Author Contributions
Funding
Acknowledgments
Conflicts of Interest
Appendix A
| Variant | Culture Substrate | Protein Addition |
|---|---|---|
| V1 (C1 A1) | classical (C1) | without protein addition (A1) |
| V2 (C1 A2) | classical (C1) | wheat bran 3% (A2) |
| V3 (C1 A3) | classical (C1) | corn flour 3% (A3) |
| V4 (C2 A1) | synthetic (C2) | without protein addition (A1) |
| V5 (C2 A2) | synthetic (C2) | wheat bran 3% (A2) |
| V6 (C2 A3) | synthetic (C2) | corn flour 3% (A3) |
| V7 (C3 A1) | mixed (C3) | without protein addition (A1) |
| V8 (C3 A2) | mixed (C3) | wheat bran 3% (A2) |
| V9 (C3 A3) | mixed (C3) | corn flour 3% (A3) |
| V10 (C4 A1) | Reed + horse manure (C4) | without protein addition (A1) |
| V11 (C4 A2) | Reed + horse manure (C4) | wheat bran 3% (A2) |
| V12 (C4 A3) | Reed + horse manure (C4) | corn flour 3% (A3) |
| Type of Compost | Components | Quantity for 1 Tone of Compost |
|---|---|---|
| C1—Classical | Horse manure (horse manure and wheat bedding straw 70–75%) | 500 kg |
| Gypsum (calcium sulphate) CaSO4·2H2O | 25 kg | |
| Superphosphate Ca(H2PO4)2·H2O | 7 kg | |
| Ammonium sulphate (NH4)2SO4 | 7 kg | |
| C2—Synthetic | Wheat straw | 350 kg |
| Poultry litter | 150 kg | |
| Gypsum (calcium sulphate) CaSO4·2H2O | 20 kg | |
| Urea CH4N2O | 7 kg | |
| C3—Mixed | Horse manure (horse manure and wheat bedding straw 70–75%) | 250 kg |
| Poultry litter | 100 kg | |
| Wheat straw | 150 kg | |
| Gypsum (calcium sulphate) CaSO4·2H2O | 24 kg | |
| Urea CH4N2O | 2 kg | |
| C4—Original | shredded reed | 100 kg |
| Horse manure (horse manure and wheat bedding straw 70–75%) | 200 kg | |
| Poultry litter | 150 kg | |
| Gypsum (calcium sulphate) CaSO4·2H2O | 24 kg | |
| Urea CH4N2O | 2 kg |


Appendix B

References
- Chang, S.T.; Mshigeni, K. Mushrooms and Human Health: Their Growing Significance as Potent Dietary Supplements; University of Namibia: Windhoek, Namibia, 2001; pp. 24–57. [Google Scholar]
- Kapoor, J.N. Mushroom Cultivation; Department of Mycology and Plant Pathology, IARI: New Delhi, India, 2004; pp. 14–15. [Google Scholar]
- Chakravarty, B. Trends in mushroom cultivation and breeding. Aust. J. Agric. Eng. 2011, 2, 102–109. [Google Scholar]
- Rózsa, S. Study of Some Technological Aspects of Agaricus blazei Murrill Mushroom Culture. Ph.D. Thesis, University of Agricultural Sciences and Veterinary Medicine Cluj-Napoca, Cluj-Napoca, Romania, 2017. [Google Scholar]
- Kubiak, K. Market of fresh and processed cultivated mushrooms in Poland. Prezem. Ferment. Owoc-Warz. 2001, 53, 50–52. [Google Scholar]
- Wasser, S.P. Medicinal mushroom science: History. current status. future trends and unsolved problems. Int. J. Med. Mushrooms 2010, 12, 1–16. [Google Scholar] [CrossRef]
- Suganya, M.; Suriyavathana, M. Antioxidant profile of Agaricus bisporus and Calocybe indica. Int. J. Pharm. Life Sci. 2012, 3, 1780–1783. [Google Scholar]
- Hobbs, C. Medicinal Mushrooms: An Exploration of Tradition. Healing & Culture; Publication Botanica Press: Williams, CA, USA, 1995; pp. 7–10. [Google Scholar]
- Yoshinura, W.; Ueda, N.; Ichioka, K.; Matsui, Y.; Terai, A.; Arai, Y. Use of complementary and alternative medicine by patients with urologic cancer: A prospective study at a single Japanese institution. Support. Care Cancer 2005, 13, 685–690. [Google Scholar] [CrossRef] [PubMed]
- Adams, C. Uncloaking the Mysteries of Medicinal Mushrooms: The U.S. Medicinal Mushroom Market Continues to Grow and Evolve Rapidly but Its Size Still Pales in Comparison to the Rest of the World; Nutraceuticals World: Montvale, NJ, USA, 2008. [Google Scholar]
- Wang, H.T.; Yang, L.C.; Yu, H.C.; Chen, M.L.; Wang, H.J.; Lu, T.J. Characteristics of fucose-containing polysaccharides from submerged fermentation of Agaricus blazei Murill. J. Food Drug Anal. 2018, 26, 678–687. [Google Scholar] [CrossRef] [PubMed]
- Venturella, G.; Saporita, P.; Gargano, M.L. The Potential Role of Medicinal Mushrooms in the Prevention and Treatment of Gynecological Cancers: A Review. Int. J. Med. Mushrooms 2019, 21, 225–235. [Google Scholar] [CrossRef]
- Firenzuoli, F.; Gori, L.; Lombardo, G. The medicinal mushroom Agaricus blazei Murrill: Review of literature and Pharmaco-toxicological problems. Evid.-Based Complement. Altern. Med. 2008, 5, 3–15. [Google Scholar] [CrossRef]
- Ayeka, P.A. Potential of Mushroom Compounds as Immunomodulators in Cancer Immunotherapy: A Review. Evid.-Based Complement. Altern. Med. 2018, 2018, 7271509. [Google Scholar] [CrossRef]
- De Souza, A.C.S.; Correa, V.G.; Goncalves, G.A.; Soares, A.A.; Bracht, A.; Peralta, R.M. Agaricus blazei Bioactive Compounds and their Effects on Human Health: Benefits and Controversies. Curr. Pharm. Des. 2017, 23, 2807–2834. [Google Scholar] [CrossRef]
- Wisitrassameewong, K.; Karunarathna, S.; Thongklang, N.; Zhao, R.L.; Callac, P.; Serge, M.; Férandon, C.; Chukeatirote, E.; Hyde, K. Agaricus subrufescens: A review. Saudi J. Biol. Sci. 2012, 19, 131–146. [Google Scholar] [CrossRef] [PubMed]
- Nieto-Mosquera, D.; Segura-Puello, H.; Segura-Charry, J.; Muñoz-Forero, D.M.; Villamil-Ballesteros, A. Immunomodulatory Fungi: An Alternative for the Treatment of Cancer. J. Cancer Tumor Int. 2019, 9, 1–13. [Google Scholar] [CrossRef]
- Stojkovic, D.; Reis, F.S.; Glamoclija, J.; Ciric, A.; Barros, L.; Van Griensven, L.J.L.D.; Ferreira, I.C.F.R.; Sokovic, M. Cultivated strains of Agaricus bisporus and A. brasiliensis: Chemical characterization and evaluation of antioxidant and antimicrobial properties for the final healthy product—Natural preservatives in yoghurt. Food Funct. 2014, 5, 1602–1612. [Google Scholar] [CrossRef] [PubMed]
- Horm, V.; Ohga, S. Potential of compost with some added Supplementary Materials on the development of Agaricus blazei Murrill. J. Fac. Agric. 2008, 53, 417–422. [Google Scholar]
- Mizuno, T. Agaricus blazei Murrill medicinal and dietary effects. Food Rev. Int. 1995, 11, 167–172. [Google Scholar] [CrossRef]
- Mizuno, T. Medicinal properties and clinical effects of culinary mushroom Agaricus blazei Murrill (Agaricomycetideae). Int. J. Med. Mushrooms 2002, 4, 299–312. [Google Scholar] [CrossRef]
- Amazonas, M.A.L. Champignon do Brasil (Agaricus brasiliensis). Nutrition. Health. Market Demands and Regulatory Concerns. Acta Edulis Fungi 2005, 12, 111–119. [Google Scholar]
- Liu, Y.; Fukuwatari, Y.; Okumura, K.; Takeda, K.; Ishibashi, K.; Furukawa, M.; Ohno, N.; Mori, K.; Gao, M.; Motoi, M. Immunomodulating Activity of Agaricus brasiliensis KA21 in Mice and Human Volunteers. Evid.-Based Complement. Altern. Med. 2008, 5, 205–219. [Google Scholar] [CrossRef]
- Chang, S.T.; Miles, P.G. Mushrooms: Cultivation, Nutritional Values, Medicinal Effect and Environmental Impact, 2nd ed.; CRC: Boca Raton, FL, USA, 2004; 451p. [Google Scholar]
- Takaku, T.; Kimura, Y.; Okuda, H. Isolation of an antitumor compound from Agaricus blazei Murrill (sic) and its mechanism of action. J. Nutr. 2001, 131, 1409–1413. [Google Scholar] [CrossRef]
- Kotwaliwale, N.; Bakane, P.; Verma, A. Changes in textural and optical properties of oyster mushroom during hot air drying. J. Food Eng. 2007, 78, 1207–1211. [Google Scholar] [CrossRef]
- Chuwa, P.C. Use of Market Waste as a Substrate for Cultivation of Edible Mushrooms. Master’s Thesis, University of Dar es Salaam, Dar es Salaam, Tanzania, 1997. [Google Scholar]
- Iwade, I.; Mizuno, T. Cultivation of Kawariharatake (Agaricus blazei Murill). Food Rev. Int. 1997, 13, 338–390. [Google Scholar] [CrossRef]
- Oei, P. Mushroom Cultivation: Appropriate Technology for Mushroom Growers, 3rd ed.; Backhuys Publishers: Leiden, The Netherlands, 2003; 429p. [Google Scholar]
- Pokhrel, C.P.; Ohga, S. Cattle bedding waste used as a substrate in the cultivation of Agaricus blazei Murill. J. Fac. Agric. Kyushu Univ. 2007, 52, 295–298. [Google Scholar]
- Siqueira, F.G.; Dias, E.S.; Silva, R.; Martos, E.T.; Rinker, D.L. Cultivation of Agaricus blazei ss. Heinemann using different soils as source of casing materials. Sci. Agric. 2009, 66, 827–830. [Google Scholar] [CrossRef]
- Largeteau, M.L.; Llarena-Hernandez, R.C.; Regnault-Roger, C.; Savoie, J.M. The medicinal Agaricus mushroom cultivated in Brazil: Biology, cultivation and non-medicinal valorization. Appl. Microbiol. Biotechnol. 2011, 92, 897–907. [Google Scholar] [CrossRef]
- Wang, Q.; Li, B.B.; Li, H.; Han, J.R. Yield, dry matter and polysaccharides content of the mushroom Agaricus blazei produced on asparagus straw substrate. Sci. Hortic. 2010, 125, 16–18. [Google Scholar] [CrossRef]
- Gern, R.M.M.; Libardi, N., Jr.; Patricio, G.N.; Wisbeck, E.; Chaves, M.B.; Furlan, S.A. Cultivation of Agaricus blazei on Pleurotus spp. spent substrate. Braz. Arch. Biol. Technol. 2010, 53, 939–944. [Google Scholar] [CrossRef]
- Chen, A. A Practical Guide to the Cultivation of Agaricus blazei: A Mushroom of Culinary and Biomedical Importance. MushWorld. 2003. Available online: http//www.mushworld.com (accessed on 29 August 2019).
- Gonzalez Matute, R.; Figlas, D.; Curvetto, N. Agaricus blazei production on non-composted substrates based on sunflower seed hulls and spent oyster mushroom substrate. World J. Microbiol. Biotechnol. 2011, 27, 1331–1339. [Google Scholar] [CrossRef]
- Schisler, L.C.; Sinden, J.W. Nutrient supplementation of mushroom compost at casing. Can. J. Bot. 1966, 4, 287–293. [Google Scholar]
- Sing, R.N.; Jain, V.B. Nutrient supplementation for good yield of button mushroom. Indian Phytopathol. 1982, 35, 535–536. [Google Scholar]
- Coello-Castillo, M.M.; Sanchez, J.E.; Royse, D.J. Production of Agaricus bisporus on substrates pre colonized by Scytalidium thermophilum and supplemented at casing with protein-rich supplements. Bioresour. Technol. 2009, 100, 4488–4492. [Google Scholar] [CrossRef]
- Zicari, G.; Rivetti, D.; Soardo, V.; Cerrato, E. The cultivation of the mushroom Agaricus bisporus (Champignon) and some environmental and health aspects. Igiene e Sanita Pubblica 2012, 68, 435–446. [Google Scholar] [PubMed]
- Wuest, P.J.; Duffy, M.D. Six Steps to Mushroom Growing; Special Circular 268; The Pennsylvania State University Extension Bulletin: University Park, PA, USA, 2013. [Google Scholar]
- Vedder, P.C. Modern Mushroom Growing; Pitman Press: Madisonville, KY, USA, 2012. [Google Scholar]
- Nogueira, M.C.; Furlan, J.P.; Vieira, F.R.; Rodrigues, S.; Fillet, M.H.; Almeida, M.T. Dynamics of the chemical composition and productivity of composts for the cultivation of Agaricus bisporus strains. Braz. J. Microbiol. 2013, 44, 1139–1146. [Google Scholar]
- Teichmann, A.; Dutta, P.C.; Staffas, A.; Jâgerstad, M. Sterol and vitamin D2 concentration in cultivated and wild grown mushrooms: Effects of UV irradiation. LWT-Food Sci. Technol. 2007, 40, 815–822. [Google Scholar] [CrossRef]
- Barreira, J.C.M.; Oliveir, M.B.P.P.; Ferreira, I.C.F.R. Development of a novel methodology for the analysis of ergosterol in mushrooms, Food Anal. Methods 2014, 7, 217–223. [Google Scholar]
- Villares, A.; Mateo-Vivaracho, L.; García-Lafuente, A.; Guillamón, E. Storage temperature and UV-irradiation influence on the ergosterol content in edible mushrooms. Food Chem. 2014, 147, 252–256. [Google Scholar] [CrossRef] [PubMed]
- Davey, M.W.; Van Montagu, M.; Inze, D.; Sanmartin, M.; Kanellis, A.; Smirnoff, N.; Benzie, I.J.J.; Strain, J.J.; Favell, D.; Fletcher, J. Plant L-ascorbic acid: Chemistry, function, metabolism, bioavailability and effects of processing. J. Sci. Food Agric. 2000, 80, 825–860. [Google Scholar] [CrossRef]
- Giovannoni, J.J. Completing a pathway to plant vitamin C synthesis. Proc. Nat. Acad. Sci. USA 2007, 104, 9109–9110. [Google Scholar] [CrossRef] [PubMed]
- Hancock, R.D.; Viola, R. Biosynthesis and catabolism of L-ascorbic acid in plants. Crit. Rev. Plant Sci. 2005, 24, 167–188. [Google Scholar] [CrossRef]
- Tsai, S.Y.; Tsai, H.L.; Mau, J. Non-volatile taste components of Agaricus blazei, Agrocybe cylindracea and Boletus edulis. Food Chem. 2008, 107, 977–983. [Google Scholar] [CrossRef]
- Carneiro, A.A.J.; Ferreira, I.C.F.R.; Dueñas, M.; Barros, L.; Da Silva, R.; Gomes, E. Chemical composition and antioxidant activity of dried powder formulations of Agaricus blazei and Lentinus edodes. Food Chem. 2013, 138, 2168–2173. [Google Scholar] [CrossRef] [PubMed]
- Cohen, N.; Cohen, J.; Asatiani, M.D.; Varshney, V.K.; Yu, H.T.; Yang, Y.C. Chemical composition and nutritional and medicinal value of fruit bodies and submerged cultured mycelia of culinary-medicinal higher Basidiomycetes mushrooms. Int. J. Med. Mushrooms 2014, 16, 273–291. [Google Scholar] [CrossRef] [PubMed]
- Mattila, P.; Konko, K.; Pihlava, J.M.; Astola, J.; Vahteristo, L.; Hietaniemi, V. Contents of vitamins, mineral elements, and some phenolic compounds in cultivated mushrooms. J. Agric. Food Chem. 2001, 49, 2343–2348. [Google Scholar] [CrossRef] [PubMed]
- Furlani, R.P.Z.; Godoy, H.T. Contents of folates in edible mushrooms commercialised in the city of Campinas, Sào Paulo, Brazil. Ciéncia Tecnol. Aliment. 2007, 27, 278–280. [Google Scholar] [CrossRef]
- Bernas, E.; Jaworska, G. Effect of microwave blanching on the quality of frozen Agaricus bisporus. Food Sci. Technol. Int. 2015, 21, 245–255. [Google Scholar] [CrossRef] [PubMed]
- Fang, Y.Z.; Yang, S.; Wu, G.Y. Free radicals, antioxidants, and nutrition. Nutrition 2002, 18, 872–879. [Google Scholar] [CrossRef]
- Hensley, K.; Benaksas, E.J.; Bolli, R.; Comp, P.; Grammas, P.; Hamdheydari, L.; Mou, S.; Pye, Q.N.; Stoddard, M.F.; Wallis, G.; et al. New perspectives on vitamin E: Gamma-tocopherol and carboxyelthylhydroxychroman metabolites in biology and medicine. Free Radic. Biol. Med. 2004, 36, 1–15. [Google Scholar] [CrossRef] [PubMed]
- Furlani, R.P.Z.; Godoy, H.T. Vitamins B1 and B2 contents in cultivated mushrooms. Food Chem. 2008, 106, 816–819. [Google Scholar] [CrossRef]
- Rios-Hurtado, A.; Torres-Torres, G.; Medina-Rivas, M.A. Chemical characterization of oyster mushrooms (Pleurotus sajor caju) grown on four organic substrates. Alimentaria 2003, 349, 85–89. [Google Scholar]
- Sturion, G.L.; Oetterer, M. Composicao Quımica de Cogumelos Comestıveis (Pleurotus spp.) Originados de Cultivos em Diferentes Substratos. Ciéncia Tecnol. Aliment. 1995, 15, 189–193. [Google Scholar]
- Edeoga, H.O.; Gomina, A. Nutritional values of some non-conventional leaf vegetables of Nigeria. J. Econ. Bot. 2000, 24, 7–12. [Google Scholar]
- Lattif, L.A.; Daran, A.B.M.; Mohammed, A.B. Relative Distribution of Minerals in the Pileus and Stalk of Some Selected Edible Mushroom. Food Chem. 1996, 56, 115–121. [Google Scholar] [CrossRef]
- Qui, U.; Lui, Y. Fruthody Production in Basidiomycetes. Appl. Microbiol. Biotechnol. 2000, 54, 141–152. [Google Scholar]
- Koyyalamudi, S.R.; Jeong, S.C.; Cho, K.Y.; Pang, G. Vitamin B12 Is the Active Corrinoid Produced in Cultivated White Button Mushrooms (Agaricus bisporus). J. Agric. Food Chem. 2009, 57, 6327–6333. [Google Scholar] [CrossRef] [PubMed]
- Banik, S. Mushrooms: The magic store of health benefits. Everyman’s Sci. 2010, 47, 360–365. [Google Scholar]
- Rózsa, S.; Măniuțiu, D.N.; Gocan, T.M.; Sima, R.; Rózsa, M. Study on chemical composition of Agaricus blazei Murrill mushroom, produced on different substrates. J. Hortic. For. Biotechnol. 2017, 21, 150–157. [Google Scholar]
- Pegg, R.B.; Eitenmiller, R.R. Vitamin Analysis. In Food Analysis; Food Science Text Series; Nielsen, S., Ed.; Springer: Cham, Switzerland, 2017; pp. 361–370. [Google Scholar]
- Rózsa, S.; Maniutiu, D.N.; Gocan, T.M.; David, S.; Butuza-Bumb, F.S. Influence of pasteurization on different composts used for Agaricus spp. mushroom cultivation on changing the ammonia concentration and the pH level. Agric. Sci. Pract. 2016, 99, 34–39. [Google Scholar] [CrossRef]











| Experimental Variants | Ergosterol (mg 100 g−1 dm) * | C Vitamin (mg 100 g−1 dm) * | B1 Vitamin (μg 100 g−1 dm) * | B2 Vitamin (μg 100 g−1 dm) * | B9 Vitamin (μg 100 g−1 dm) * | B12 Vitamin (μg 100 g−1 dm) * | PP Vitamin (mg 100 g−1 dm) * |
|---|---|---|---|---|---|---|---|
| V1 | 87.33bc | 18.50b | 1030c | 4983b | 579d | 518h | 43.00e |
| V2 | 90.17b | 19.17ab | 1100b | 5450a | 598c | 531gh | 45.67d |
| V3 | 94.00a | 21.50a | 1151a | 5616a | 631b | 558fg | 49.67c |
| V4 | 82.17d | 12.67gf | 900e | 3816e | 435g | 703e | 29.67h |
| V5 | 82.67d | 15.00def | 940d | 4316d | 458f | 728e | 31.67h |
| V6 | 84.83cd | 15.67cde | 956d | 4550cd | 475e | 761d | 35.00g |
| V7 | 82.33d | 18.00bc | 573g | 4800bc | 618b | 828c | 50.00bc |
| V8 | 82.33d | 19.17ab | 616f | 4983b | 631b | 866b | 52.17b |
| V9 | 87.50bc | 21.67a | 635f | 5350a | 671a | 906a | 55.33a |
| V10 | 73.00f | 11.00g | 381i | 3183g | 283i | 463i | 35.67g |
| V11 | 74.17ef | 16.67ef | 395hi | 3450fg | 291i | 538gh | 38.33f |
| V12 | 77.00e | 17.00bcd | 423h | 3533ef | 313h | 573f | 40.00f |
| SD | 3.34–3.85 | 2.38–2.74 | 35.68–41.15 | 309.23–356.65 | 13.77–15.88 | 32.40–37.37 | 2.38–2.75 |
© 2019 by the authors. Licensee MDPI, Basel, Switzerland. This article is an open access article distributed under the terms and conditions of the Creative Commons Attribution (CC BY) license (http://creativecommons.org/licenses/by/4.0/).
Share and Cite
Rózsa, S.; Măniuțiu, D.-N.; Poșta, G.; Gocan, T.-M.; Andreica, I.; Bogdan, I.; Rózsa, M.; Lazăr, V. Influence of the Culture Substrate on the Agaricus blazei Murrill Mushrooms Vitamins Content. Plants 2019, 8, 316. https://doi.org/10.3390/plants8090316
Rózsa S, Măniuțiu D-N, Poșta G, Gocan T-M, Andreica I, Bogdan I, Rózsa M, Lazăr V. Influence of the Culture Substrate on the Agaricus blazei Murrill Mushrooms Vitamins Content. Plants. 2019; 8(9):316. https://doi.org/10.3390/plants8090316
Chicago/Turabian StyleRózsa, Sándor, Dănuț-Nicolae Măniuțiu, Gheorghe Poșta, Tincuța-Marta Gocan, Ileana Andreica, Ileana Bogdan, Melinda Rózsa, and Vasile Lazăr. 2019. "Influence of the Culture Substrate on the Agaricus blazei Murrill Mushrooms Vitamins Content" Plants 8, no. 9: 316. https://doi.org/10.3390/plants8090316
APA StyleRózsa, S., Măniuțiu, D.-N., Poșta, G., Gocan, T.-M., Andreica, I., Bogdan, I., Rózsa, M., & Lazăr, V. (2019). Influence of the Culture Substrate on the Agaricus blazei Murrill Mushrooms Vitamins Content. Plants, 8(9), 316. https://doi.org/10.3390/plants8090316

